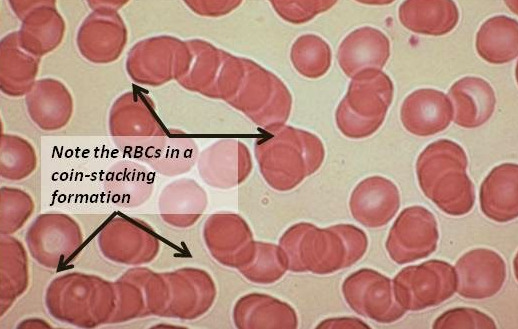
Coin-Stacking-RBC-Rouleaux-formation.jpg

빈혈, 철분제만 먹으면 될까요?
건강검진 등으로 받는 피검사에서 혈색소(hemoglobin) 수치가 감소되는 경우를 빈혈이라고 합니다. 빈혈이 생기면 혈액이 인체 조직의 대사에 필요한 산소를 충분히 공급하지 못해 조직의 저산소증을 초래하게 됩니다. 산소가 부족하니 우리 몸 곳곳에 산소가 공급되지 않아 피로, 쇠약감, 창백한 피부, 숨이 차는 증상, 가슴이 두근거리고, 두통, 어지럼증, 팔다리의 저린 감각 등의 다양한 증상을 환자들이 호소합니다.
만 10세 이상의 빈혈 유병률은 2007년 9.5%에서 2019년 6.9%로 2.6% 가 감소하였으나 여전히 발생빈도가 높습니다. 또한, 2019년 기준 여자의 빈혈 유병률은 11.5%로 남자(2.6%)에 비해 4.4배 높습니다. (그림 1)

출처 : 2019년 국민건강통계, http://knhanes.kdca.go.kr/
이렇듯 여전히 흔하게 발생하는 질환이다 보니 일반인들은 빈혈이라고 하면 '철분제만 먹으면 되는 거 아닌가요? 철분제 약국에서 사 먹을게요.'라고 하는 경우가 종종 있습니다.
하지만 빈혈은 철결핍성 빈혈, 거대적아구성 빈혈, 재생불량성 빈혈, 골수 질환과 관련된 빈혈, 용혈성 빈혈 등 다양한 원인이 있고 정확한 원인을 파악하지 않고 시기가 지나고 늦게 발견되면, 치료가 제때에 이루어지지 않아 환자의 예후가 좋지 않기도 합니다.
2023년 4월 말, 호흡기내과에서 의뢰가 왔습니다. 폐렴으로 환자가 입원하였고, 담낭염이 의심되어 환자에 대한 적절한 치료를 문의하였습니다. 66세 여자환자분이었고, 뭔가 지쳐 보이고 전신쇄약이 관찰되었습니다. 폐렴이 걸리면 물론 발생할 수 있지만, CT에서 보이는 소견보다 더 몸이 좋아 보이지 않았습니다. 복부 CT에서 담낭염, 담도염이 의심되어 내시경 초음파(EUS)를 시행하였고, EUS에서는 담낭(쓸개)에 다량의 찌꺼기(sludge)만 있고 담도에 특이소견 없고 우상복부 통증이 없어 약물치료만 해도 된다고 판단되었습니다.
하지만, 환자의 피검사를 보았을 때 이상소견이 있었으니....
WBC Count(백혈구 수) : 6.09 4.0 ~ 10.0 x10^3/uL
RBC Count(적혈구 수) : 1.63 4.0 ~ 6.0 L x10^6/uL
Hb(hemoglobin-혈색소) : 5.6 12.0 ~ 16.0 L g/dL
Hct(적혈구 용적률) : 16.7 36.0 ~ 47.0 L %
MCV(평균 적혈구 용적) : 102.5 80 ~ 100.0 H fl
MCH(평균 적혈구 혈색소량) : 34.4 28.2 ~ 33.3 H pg
MCHC(평균 적혈구 혈색소 : 33.5 32.0 ~ 36.0g/dL
Platelet count(혈소판 수) : 108 150 ~ 450 L x10^3/uL
S-Iron [Fe](철) : 28.8 40 ~ 188 L ug/dL
UIBC(불포화철결합능) : 128.1 137 ~ 325 L ug/dL
혈색소가 5.6 밖에 되지 않아 몸의 피가 반도 없는 매우 심한 빈혈소견이 관찰되었습니다. 또한 철 결핍소견도 있었습니다. 보호자와 환자에게 물어보았을 때, 지역의원에서 철결핍성 빈혈이 의심되어 장기간 철분제를 복용했다고 하였습니다.
하지만 장기간 철분제를 복용했는 데 빈혈이 계속된다? 그건 이상한 것이었습니다.
Total Protein(총 단백) : 11.5 6.7 ~ 8.3 H g/dL
Albumin(알부민) : 2.4 3.8 ~ 5.3 L g/dL
이 검사도 일반적인 빈혈에서 발생하지 않고 혈액질환이 있을 때 관찰되는 소견이었습니다.
무언가 이상하다고 판단되어 말초혈액도말검사를 시행하였고,
그림 2 Rouleaux formation (적혈구 연전현성)
현미경 검사상 적혈구가 동전을 쌓아 올려놓은 것과 같은 형태를 이루는 적혈구 연전현성(Rouleaux formation) 이 관찰되어 다발성 골수종(multiple myeloma) 이 합당하다고 판단되었습니다.
이 경우 혈청 또는 소변 검사를 통한 M단백의 존재, 골수검사에서 형질세포의 증가, 골조직검사에서 형질세포종양의 존재, 뼈 단순촬영에서 공의 융해성 병적 변화의 존재 등을 확인해야 하며, 정확한 진단 및 치료를 위해 혈액종양내과에 환자를 전과하였습니다.
다발성골수종은 1기인 경우는 별다른 치료 없이 3~6개월 정도의 간격으로 주기적인 관찰을 하고, 진행되거나 또는 아밀로이드증, 과칼슘혈증, 신기능이상, 빈혈, 뼈의 병리적 변화, 과점도증후군, 반복적인 감염 등의 증상이 있는 경우 적극적인 치료를 합니다. 증상이 있는 2기 이상에서는 항암 화학요법 치료를 하게 되며, 경우에 따라 자가 조혈모세포 이식, 또는 동종 조혈모세포 이식을 하게 됩니다.
병의 진행 단계, 즉 병기는 1기, 2기 및 3기로 나눌 수 있고, 분류하는 방식은 크게 두 가지, 즉 듀리-새먼 기준(Durie-Salmon criteria)과 국제 병기분류 체계(International staging system; ISS)가 있습니다. 전자에 따르면 혈색소, 칼슘, 뼈의 병리적 변화 유무 및 개수, M단백의 양, 신장기능에 따라 병기가 결정되고, 후자에 따르면 알부민과 베타 2-마이크로글로불린 수치에 의해 병기가 결정됩니다. 중간 생존 개월수는 전자에 따르면 1기, 2기, 3기가 각각 61개월, 55개월, 15~30개월이고, 후자에 따르면 1기, 2기, 3기가 각각 62개월, 44개월, 29개월입니다.
이처럼, 빈혈은 흔하지만, 쉽고 단순한 질환이 아닙니다. 빈혈이 진단되면 전문의와 상담을 통해 어떤 검사를 해야 하고, 어떤 질환을 의심해야 할지 상담을 꼭 해야 합니다.
다음 시간에는 흔하지만 놓치면 안되는 철결핍성 빈혈의 원인에 대해 알아보겠습니다.
